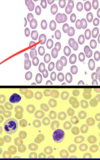
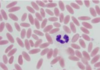
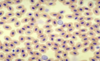

1-This image showing:
a) Nutmeg seeds
b) Colocynth capsule
c) Datura capsule
d) Jalap root

b) Colocynth capsule
2-The active ingredient(s)of it is/are:
a) Atropine, hyoscine & hyoscyamine
b) Colocynthin
c) Croton oil
d) Myristicin oil

b) Colocynthin
3- Its action(s) is/are:
a) CNS stimulation followed by depression
b) Hallucinogenic
c) Drastic purgative& abortificient
d) Cardiotoxicity

c) Drastic purgative& abortificient
4-This image showing:
a) Nutmeg seeds
b) Colocynth capsule
c) Datura capsule
d) Jalap root

c) Datura capsule
5-The active ingredient(s)of it is/are:
a) Atropine, hyoscine & hyoscyamine
b) Colocynthin
c) Croton oil
d) Castor oil

a) Atropine, hyoscine & hyoscyamine
6-The active ingredient(s)of this root is/are:
a) Myristicin oil
b) Atropine, hyoscine & hyoscyamine
c) Jalapin
d) Croton oil

c) Jalapin
7- Its action(s) is/are:
a) CNS stimulation followed by depression
b) Hallucinogenic
c) Drastic purgative& abortificient
d) Cardiotoxicity

c) Drastic purgative& abortificient
8-The given seeds are:
a) Datura fastiosa seeds
b) Datura stramonium seeds
c) Nutmeg seeds
d) Castor oil seeds

c) Nutmeg seeds
9-The active ingredient(s) of these seeds is/are:
a) Colocynthin
b) Castor oil
c) Atropine, hyoscine & hyoscyamine
d) Myristicin oil

d) Myristicin oil
10-Their action(s) is/are:
a) Cardiotoxicity
b) Drastic purgative& abortificient
c) CNS stimulation followed by depression
d) Hallucinogenic

d) Hallucinogenic
11-The given seeds are:
a) Croton oil seeds
b) Colocynth seed
c) Nutmeg seeds
d) Castor oil seeds

d) Castor oil seeds
12-The active ingredient(s) of these seeds is/are:
a) Colocynthin
b) Castor oil
c) Atropine, hyoscine & hyoscyamine
d) Croton oil

b) Castor oil
13-Their action(s) is/are:
a) Cardiotoxicity
b) Drastic purgative& abortificient
c) CNS stimulation followed by depression
d) Hallucinogenic

b) Drastic purgative& abortificient
14-The given seeds are:
a) Croton oil seeds
b) Colocynth seed
c) Nutmeg seeds
d) Castor oil seeds

a) Croton oil seeds
15-The active ingredient(s) of these seeds is/are:
a) Colocynthin
b) Castor oil
c) Atropine, hyoscine & hyoscyamine
d) Croton oil

b) Castor oil
16-Their action(s) is/are:
a) Cardiotoxicity
b) Drastic purgative& abortificient
c) CNS stimulation followed by depression
d) Hallucinogenic

b) Drastic purgative& abortificient
17-The given seeds are:
a) Croton oil seeds
b) Colocynth seed
c) Nutmeg seeds
d) Castor oil seeds

b) Colocynth seed
18-The active ingredient(s) of these seeds is/are:
a) Colocynthin
b) Castor oil
c) Atropine, hyoscine & hyoscyamine
d) Croton oil

a) Colocynthin
19-Their action(s) is/are:
a) Cardiotoxicity
b) Drastic purgative& abortificient
c) CNS stimulation followed by depression
d) Hallucinogenic

b) Drastic purgative& abortificient
20-The given seeds are:
a) Datura fastiosa seeds
b) Datura stramonium seeds
c) Nutmeg seeds
d) Castor oil seeds

b) Datura stramonium seeds
21-The active ingredient(s) of these seeds is/are:
a) Colocynthin
b) Castor oil
c) Atropine, hyoscine & hyoscyamine
d) Croton oil

c) Atropine, hyoscine & hyoscyamine
22-These seeds should be differentiated from:
a) Sesame seeds
b) Capsicum seeds
c) Onion seeds
d) Egg plant seeds

c) Onion seeds
23-The given seeds are:
a) Datura fastiosa seeds
b) Datura stramonium seeds
c) Nutmeg seeds
d) Castor oil seeds

a) Datura fastiosa seeds
24-The active ingredient(s) of these seeds is/are:
a) Colocynthin
b) Castor oil
c) Atropine, hyoscine & hyoscyamine
d) Croton oi

c) Atropine, hyoscine & hyoscyamine